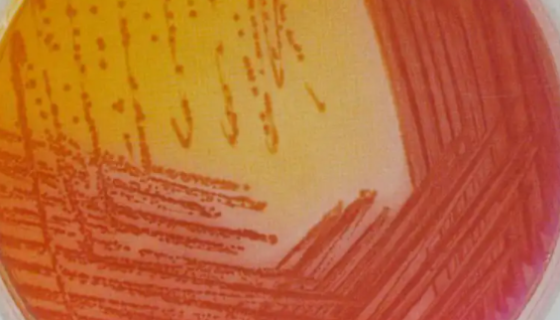
产气肠杆菌的菌体形态与生化反应及临床意义！
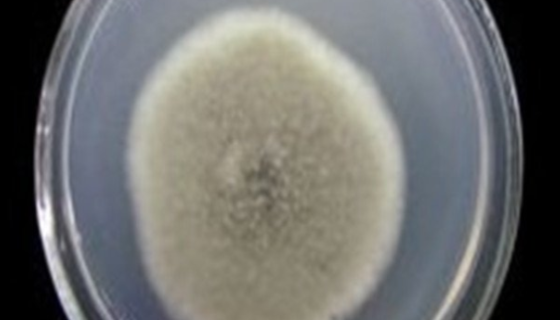
苹果黑腐皮壳的形态特征与培养条件及注意事项！

产气肠杆菌的菌体形态与生化反应及临床意义!
产气肠杆菌(Enterobacter aerogenes)系...

屎肠球菌的多种应用!百欧博伟生物
屎肠球菌是活体微生物,可以通过动物的消化道生物的竞争性排斥作...
苹果黑腐皮壳的形态特征与培养条件及注意事项!
苹果黑腐皮壳是Valsa属的微生物,原产地为中国。主要用途为...

变形链球菌的特性与致病原因及相关研究!
变形链球菌(Streptococcus mutans )为革...

鼠李糖乳杆菌的功能特性及应用价值和发展前景!
鼠李糖乳杆菌(LGG)是一种无毒、无副作用的益生菌,其功能特...

金黄色葡萄球菌产生的毒素及其毒性作用!
金黄色葡萄球菌属于葡萄球菌属,革兰氏阳性菌,需氧或兼性厌氧。...

枯草芽孢杆菌的菌株来源与水上形态及应用范围!
枯草芽孢杆菌是芽孢杆菌属的一种,生长、繁殖速度较快,在污水处...

ATCC VR-867 猫传染性腹膜炎病毒
猫传染性腹膜炎病毒的知识解析及预防和控制。

NCI-H292(人肺癌细胞(淋巴结转移))
人肺癌细胞源自肺支气管黏液上皮样癌的淋巴结转移灶;先用成份限...